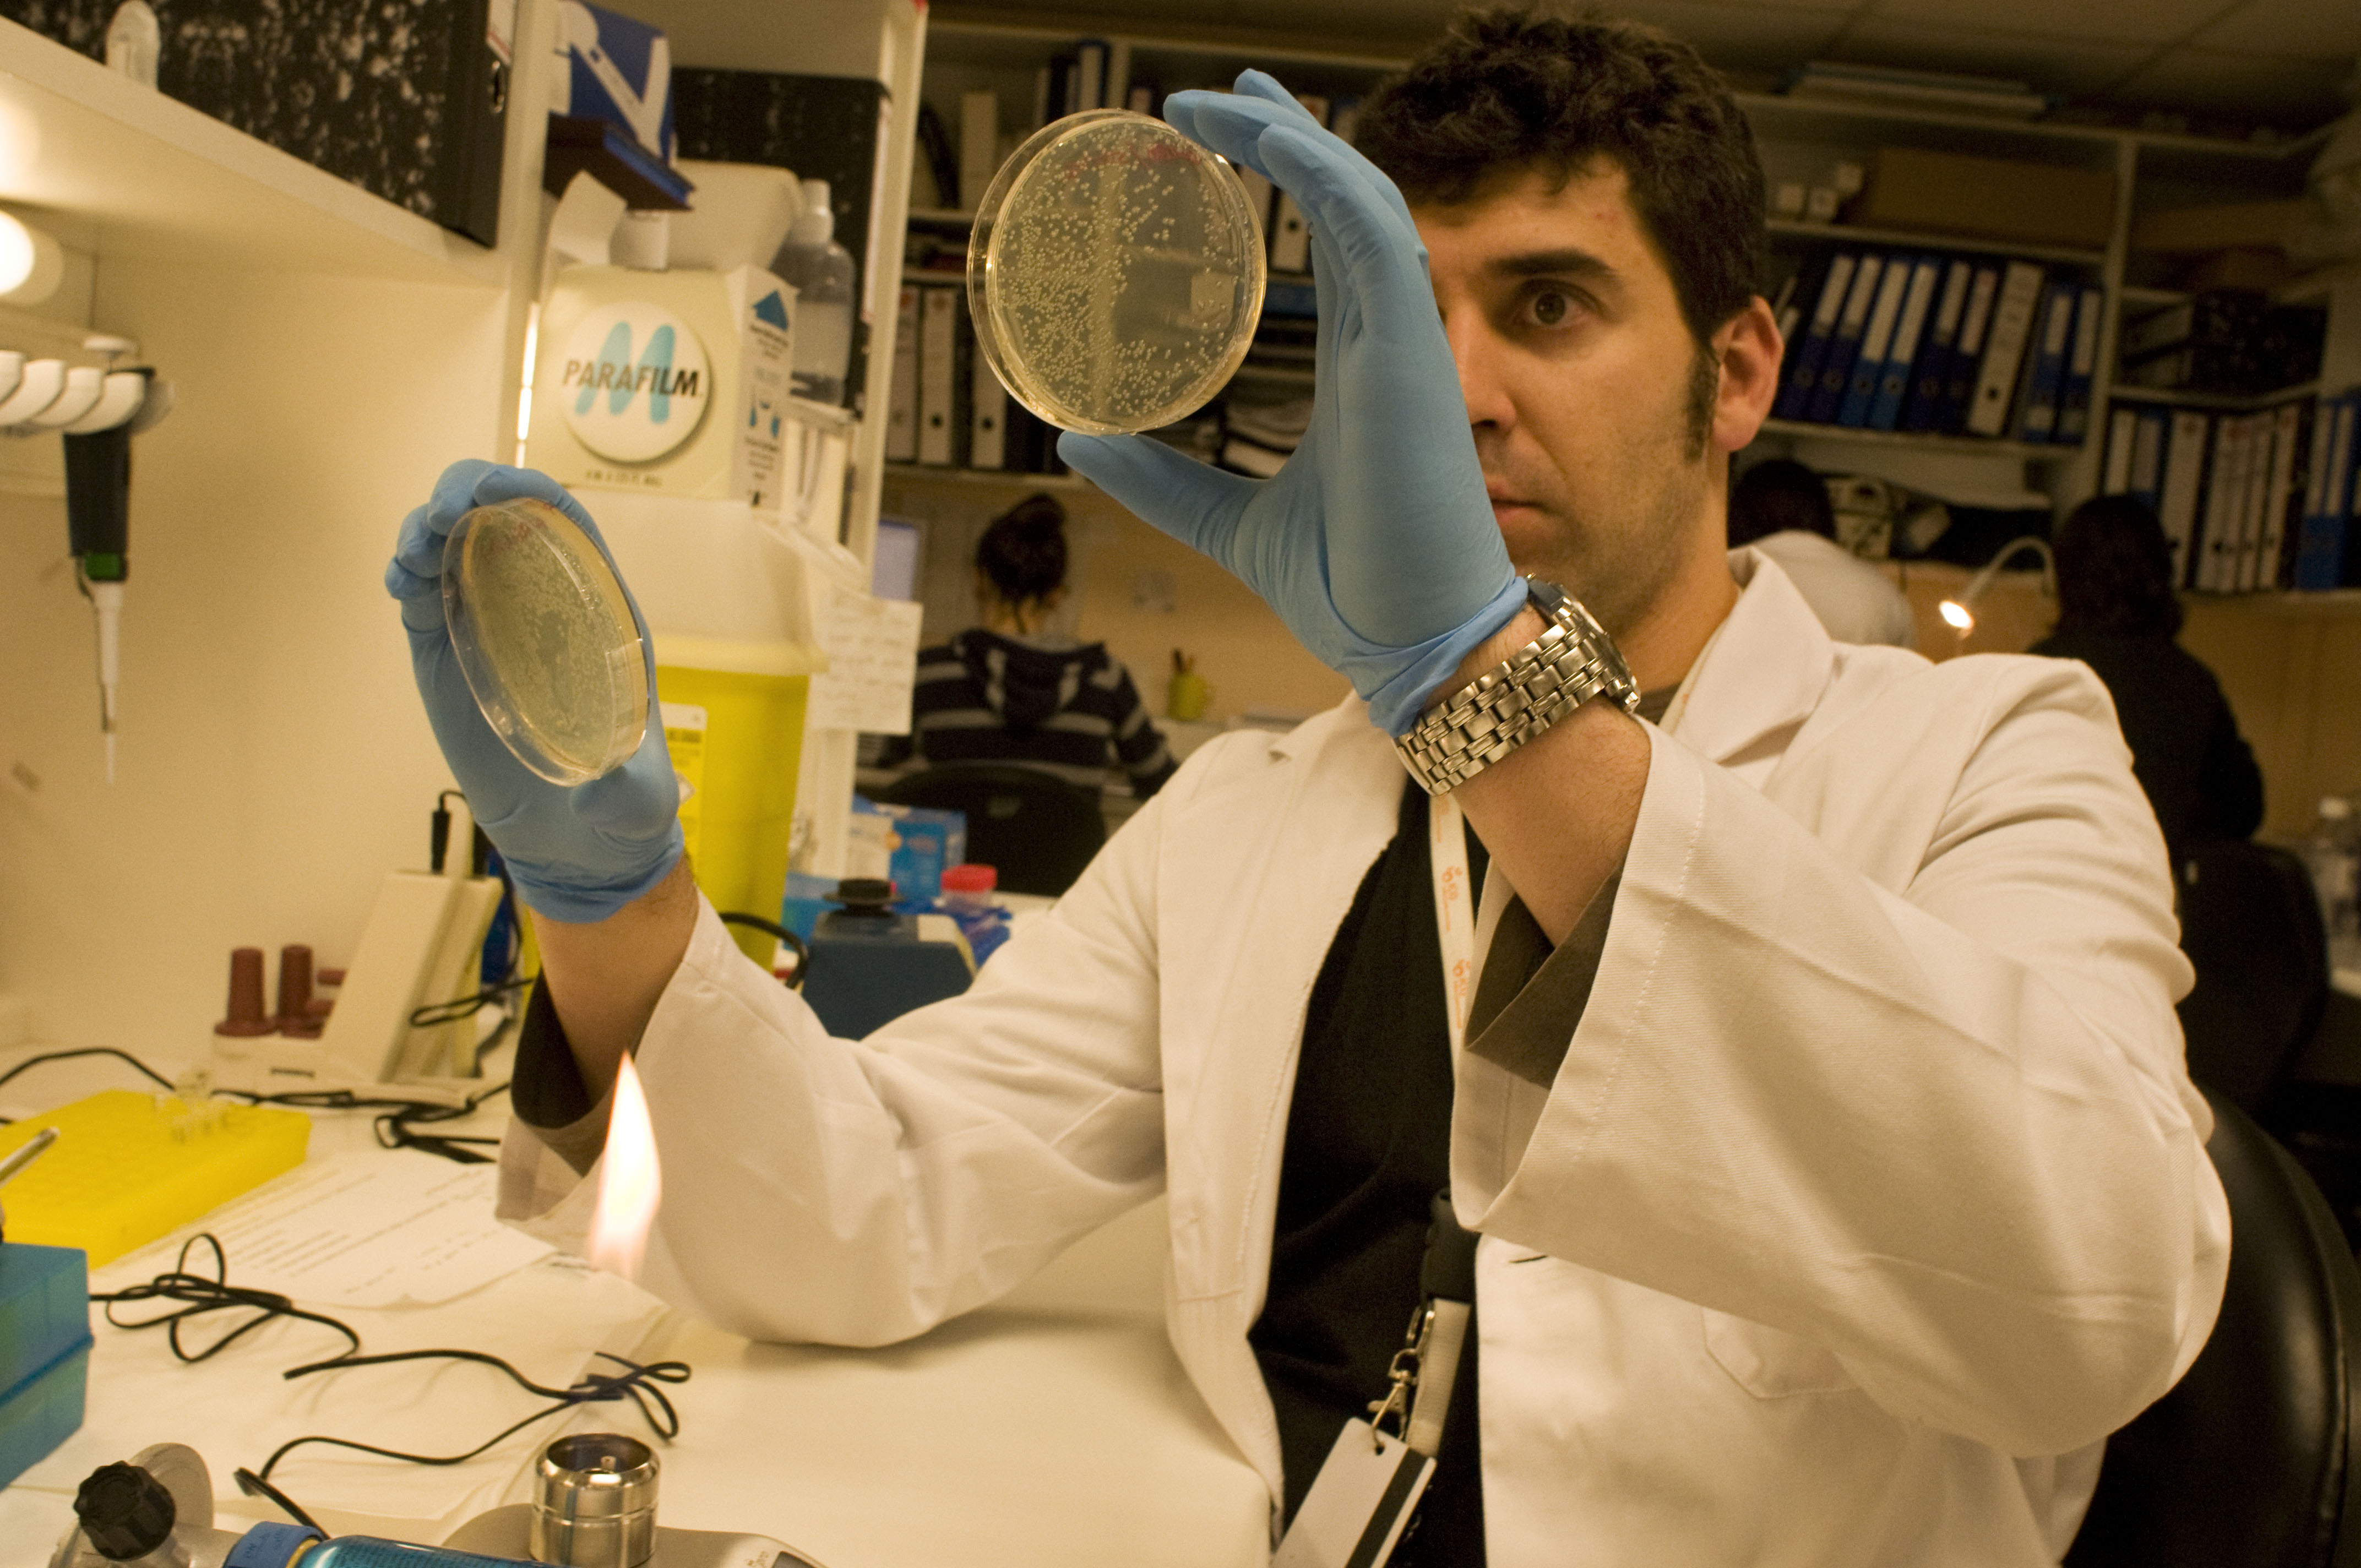
El investigador Alvaro Aytes El investigador Alvaro Aytes. Fuente: Idibell.

Un estudio de la Universidad de Columbia de Nueva York, en colaboración con el Instituto Catalán de Oncología-Instituto de Investigación Biomédica de Bellvitge (ICO-Idibell), ha identificado dos nuevos genes que conducen a formas más agresivas de cáncer de próstata. El trabajo se ha publicado en el último número de Cancer Cell.
La investigación ha sido realizada por Álvaro Aytes bajo la dirección de Cory Abate-Shen, directora del Herbert Irving Comprehensive Cancer Center de la Universidad de Columbia, señala la nota de prensa de Idibell.
Es un tumor muy asociado a edades avanzadas, y la mayoría de casos se diagnostican entre los 70 y los 80 años. El progresivo envejecimiento de la población ha hecho que sea uno de los tumores que más ha aumentado en las últimas décadas. La supervivencia es bastante elevada: según datos del Plan Director de Oncología, el 84% de los pacientes siguen vivos cinco años después del diagnóstico.
En una proporción importante de pacientes el tumor de próstata tiene un comportamiento poco agresivo, que no compromete la salud ni la calidad de vida del afectado. Además, muchas veces la persona fallece con el tumor pero no a consecuencia de éste.
Por ello es necesario el desarrollo de herramientas que permitan predecir qué tumores de próstata serán clínicamente relevantes y potencialmente letales. Esto abriría la puerta a personalizar los tratamientos y evitar ciertas terapias y, por lo tanto, los efectos secundarios que comportan, a los pacientes que no lo necesitan, reduciendo, además, el coste sanitario.
Dos nuevos genes
El estudio que publica Cancer Cell ha identificado dos genes, el FOXM1 y el CENPF, que si se activan de manera anómala a la vez, conducen a formas más agresivas y potencialmente letales del cáncer de próstata.
La investigación ha sido realizada por Álvaro Aytes bajo la dirección de Cory Abate-Shen, directora del Herbert Irving Comprehensive Cancer Center de la Universidad de Columbia, señala la nota de prensa de Idibell.
Es un tumor muy asociado a edades avanzadas, y la mayoría de casos se diagnostican entre los 70 y los 80 años. El progresivo envejecimiento de la población ha hecho que sea uno de los tumores que más ha aumentado en las últimas décadas. La supervivencia es bastante elevada: según datos del Plan Director de Oncología, el 84% de los pacientes siguen vivos cinco años después del diagnóstico.
En una proporción importante de pacientes el tumor de próstata tiene un comportamiento poco agresivo, que no compromete la salud ni la calidad de vida del afectado. Además, muchas veces la persona fallece con el tumor pero no a consecuencia de éste.
Por ello es necesario el desarrollo de herramientas que permitan predecir qué tumores de próstata serán clínicamente relevantes y potencialmente letales. Esto abriría la puerta a personalizar los tratamientos y evitar ciertas terapias y, por lo tanto, los efectos secundarios que comportan, a los pacientes que no lo necesitan, reduciendo, además, el coste sanitario.
Dos nuevos genes
El estudio que publica Cancer Cell ha identificado dos genes, el FOXM1 y el CENPF, que si se activan de manera anómala a la vez, conducen a formas más agresivas y potencialmente letales del cáncer de próstata.
Una de las novedades del estudio es que se han utilizado algoritmos informáticos para generar redes de las interacciones entre las moléculas que se generan específicamente en el cáncer de próstata.
Se han puesto en marcha estudios preclínicos para determinar qué tratamientos o combinaciones de fármacos son más eficaces para combatir la activación anómala de los genes FOXM1 y CENPF. Asimismo, en un futuro cercano, identificar la presencia o no de estos biomarcadores en un paciente concreto permitirá ofrecer un tratamiento individualizado, más eficaz y con menos efectos secundarios.
Financiación
La Comisión Europea, a través de les acciones Marie Curie del 7 Programa Marco, ha sido la fuente de financiación de Álvaro Aytes para el desarrollo del proyecto.
El cáncer de próstata es el más frecuente en los hombres (supone el 20% de todos los tumores masculinos). La incidencia es de unos 60 nuevos casos por 100.000 habitantes y año. En Catalunya se dan cerca de 5.000 casos nuevos al año y, en toda España, unos 25.000.
Se han puesto en marcha estudios preclínicos para determinar qué tratamientos o combinaciones de fármacos son más eficaces para combatir la activación anómala de los genes FOXM1 y CENPF. Asimismo, en un futuro cercano, identificar la presencia o no de estos biomarcadores en un paciente concreto permitirá ofrecer un tratamiento individualizado, más eficaz y con menos efectos secundarios.
Financiación
La Comisión Europea, a través de les acciones Marie Curie del 7 Programa Marco, ha sido la fuente de financiación de Álvaro Aytes para el desarrollo del proyecto.
El cáncer de próstata es el más frecuente en los hombres (supone el 20% de todos los tumores masculinos). La incidencia es de unos 60 nuevos casos por 100.000 habitantes y año. En Catalunya se dan cerca de 5.000 casos nuevos al año y, en toda España, unos 25.000.
Referencia bibliográfica:
Alvaro Aytes et al.: Cross-Species Regulatory Network Analysis Identifies a Synergistic Interaction between FOXM1 and CENPF that Drives Prostate Cancer Malignancy. Cancer Cell (2014). DOI: http://dx.doi.org/10.1016/j.ccr.2014.03.017
Alvaro Aytes et al.: Cross-Species Regulatory Network Analysis Identifies a Synergistic Interaction between FOXM1 and CENPF that Drives Prostate Cancer Malignancy. Cancer Cell (2014). DOI: http://dx.doi.org/10.1016/j.ccr.2014.03.017

 Tendencias Científicas
Tendencias Científicas

El corazón débil también daña al cerebro
El corazón débil también daña al cerebro CIENCIA ON LINE
CIENCIA ON LINE